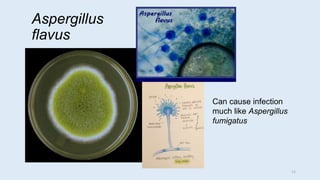
Aspergillus
flavus
Can cause infection
much like Aspergillus
fumigatus
11
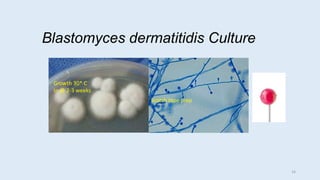
Blastomyces dermatitidis Culture
Scotch tape prep
Growth 30* C
In @ 2-3 weeks
16

Embed presentation
Downloaded 137 times






























This document provides a summary of important fungal infections seen in tissue samples under the microscope. It describes key characteristics of common molds and yeasts that cause infection, including Aspergillus, Mucor, Fusarium, Blastomyces, Coccidioides, Histoplasma, Cryptococcus, and Candida. For each fungus, the document outlines features visible in tissue, such as hyphal morphology, budding patterns, and staining properties. It also provides images comparing fungal structures and growth patterns on culture. The goal is to enable pathologists to accurately identify fungal pathogens in clinical specimens.